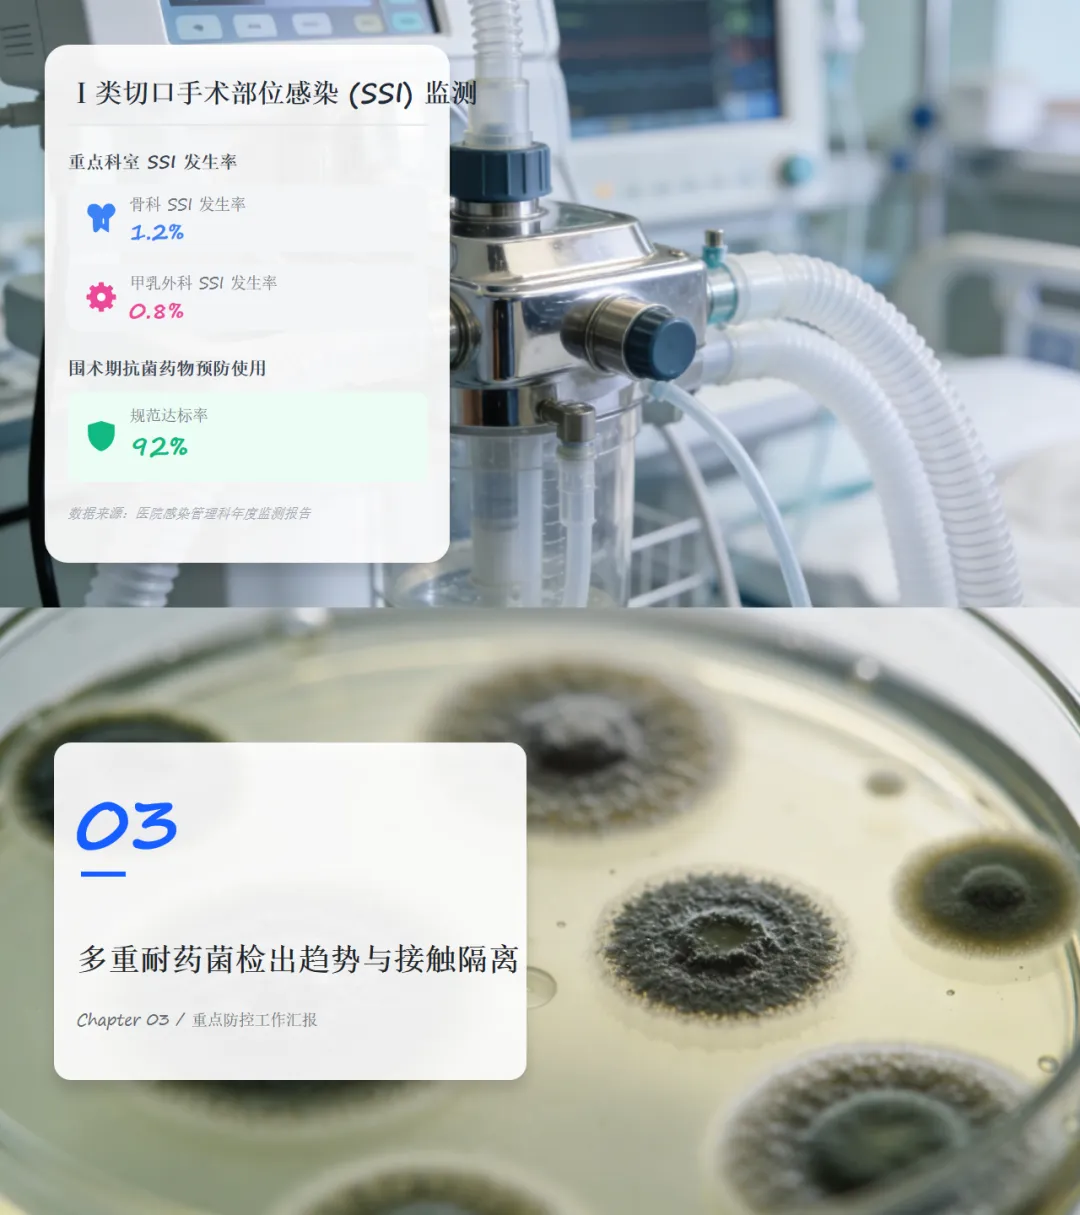
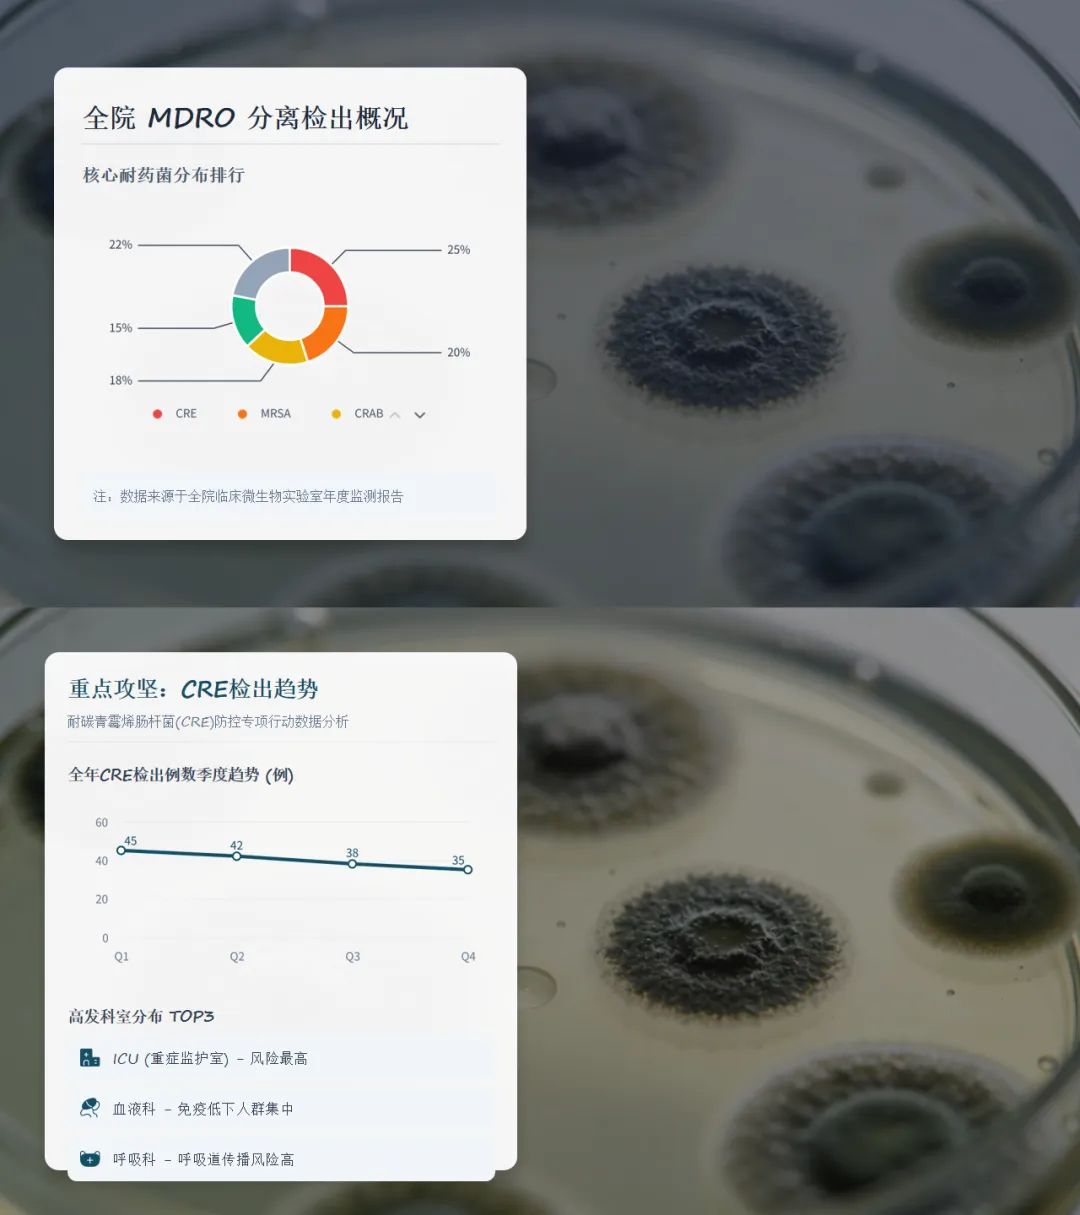
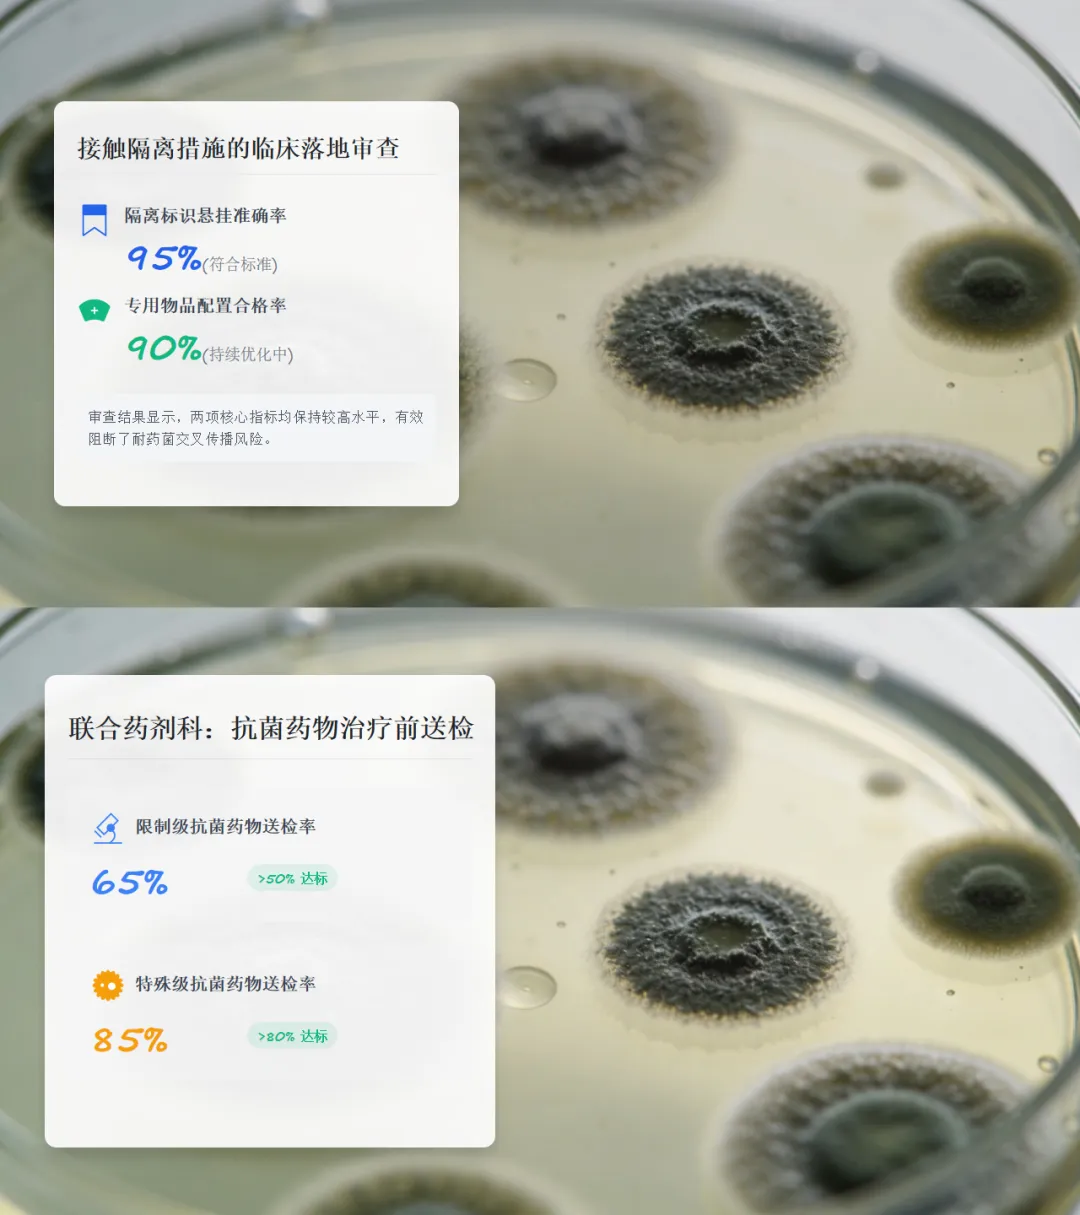

完整PPT预览
文 章 底 部 获 取 原 版 PPT


1. 内容: 【PPT课件】医院感染控制与质量管理年度工作汇报PPT+宣讲稿
2. 页数:共35页,无水印可二次编辑
3. 目录:
01 年度核心指标与目标完成情况
02 重点器械与手术部位目标性监测
03 多重耐药菌检出趋势与接触隔离
04 重点部门巡查与 PDCA 持续改进
05 手卫生依从性与医务人员职业防护
06 分层级培训与感控安全文化
07 当前挑战与下一年度战略部署

#医院感染管理年度工作汇报#院感科年终总结PPT#多重耐药菌目标性监测#MDRO接触隔离规范#PDCA院感持续质量改进#手卫生依从性考核标准#医务人员职业暴露PEP阻断#重点部门院感巡查标准#医疗废物分类管理流程#院感发病率与漏报率控制#手术部位感染SSI监测